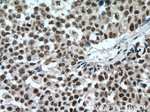
SP1 Antibody in Immunohistochemistry (Paraffin) (IHC (P))
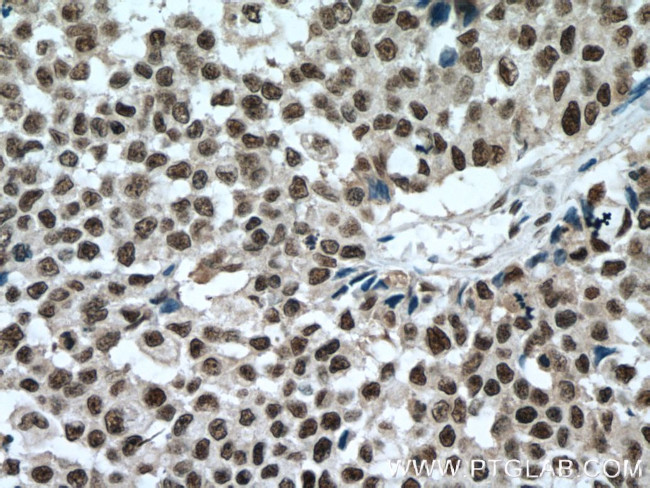
SP1 Antibody in Immunohistochemistry (Paraffin) (IHC (P))

Search
Proteintech
SP1 Monoclonal Antibody (4G3H3)
{{$productOrderCtrl.translations['antibody.pdp.commerceCard.promotion.promotions']}}
{{$productOrderCtrl.translations['antibody.pdp.commerceCard.promotion.viewpromo']}}
{{$productOrderCtrl.translations['antibody.pdp.commerceCard.promotion.promocode']}}: {{promo.promoCode}} {{promo.promoTitle}} {{promo.promoDescription}}. {{$productOrderCtrl.translations['antibody.pdp.commerceCard.promotion.learnmore']}}

Please note: We are reviewing Western blot images included in the antibody testing data in our catalog, including those provided by third parties. Unless expressly labeled or annotated as “raw-unedited”, Western blot images included in the antibody testing data in our catalog may have been edited, optimized or otherwise adjusted for presentation.
产品信息
66508-1-IG
种属反应
宿主/亚型
分类
类型
克隆号
抗原
偶联物
形式
浓度
规格
纯化类型
保存液
内含物
保存条件
运输条件
产品详细信息
Immunogen sequence: NLQLQAVPN SGPIIIRTPT VGPNGQVSWQ TLQLQNLQVQ NPQAQTITLA PMQGVSLGQT SSSNTTLTPI ASAASIPAGT VTVNAAQLSS MPGLQTINLS ALGTSGIQVH PIQGLPLAIA NAPGDHGAQL GLHGAGGDGI HDDTAGGEEG ENSPDAQPQA GRRTRREACT CPYCKDSEGR GSGDPGKKKQ HICHIQGCGK VYGKTSHLRA HLRWHTGERP FMCTWSYCGK RFTRSDELQR HKRTHTGEKK FACPECPKRF MRSDHLSKHI KTHQNKKGGP GVALSVGTLP LDSGAGSEGS GTATPSALIT TNMVAMEAIC PEGIARLANS GINVMQVADL QSINISGNGF (437-785 aa encoded by BC062539)
靶标信息
SP1 is a transcription factor that can activate or repress transcription in response to physiological and pathological stimuli. Binds with high affinity to GC-rich motifs and regulates the expression of a large number of genes involved in a variety of processes such as cell growth, apoptosis, differentiation and immune responses. Highly regulated by post-translational modifications (phosphorylations, sumoylation, proteolytic cleavage, glycosylation and acetylation). Binds also the PDGFR-alpha G-box promoter. May have a role in modulating the cellular response to DNA damage. Implicated in chromatin remodeling. Plays a role in the recruitment of SMARCA4/BRG1 on the c-FOS promoter. Plays an essential role in the regulation of FE65 gene expression.
仅用于科研。不用于诊断过程。未经明确授权不得转售。
生物信息学
蛋白别名: HGNC:11205; Specificity protein 1; trans-acting transcription factor 1; Transcription factor Sp1
基因别名: 1110003E12Rik; AA450830; AI845540; Sp1; Sp1-1
UniProt ID: (Mouse) O89090, (Rat) Q01714
Entrez Gene ID: (Mouse) 20683, (Rat) 24790